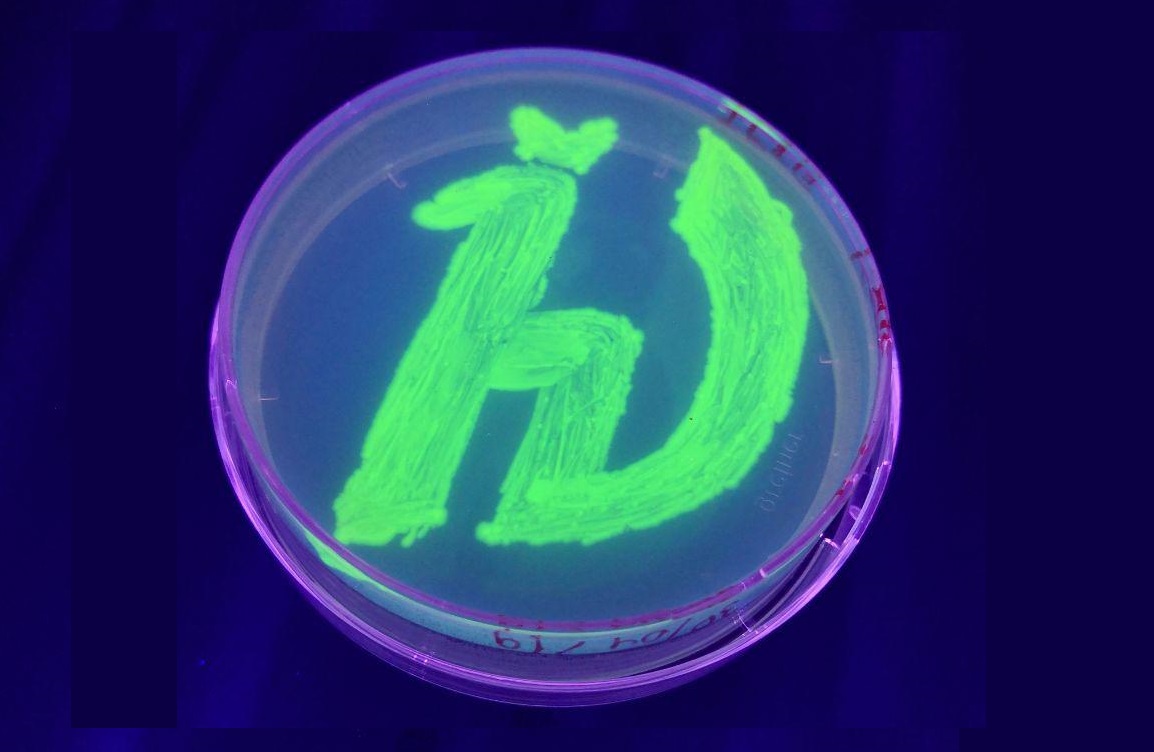

Флуоресцентного белка
Дальность вог
Песня любите женщину без
Гисметео в юртах
С днем учителя химии картинки
Отец короля англии
Комику александру гудкову
3 м 25 см
Концептуальные особенности
Мини бизнес как начать
Пляска скоморохов из оперы римского корсакова
Robert 3
Изготовить детский костюм
Отель хазбин песня know you didn t
Флуоресцентного белка 113 фотографий